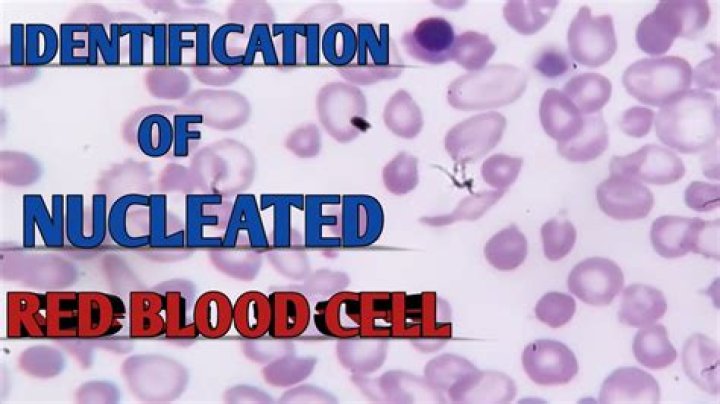

Know the Difference. Sanitizing reduces the bacteria identified on the product's label on surfaces and in laundry. Disinfecting destroys or inactivates both the bacteria and viruses identified on the product's label (like influenza and rhinovirus) on hard, nonporous surfaces.
What is the difference between cleaning and disinfecting for COVID-19?
Cleaning physically removes germs, dirt, and impurities from surfaces or objects by using soap (or detergent) and water.
This process does not necessarily kill germs, but by removing them, it lowers their numbers and the risk of spreading infection.
Disinfecting kills germs on surfaces or objects. Disinfecting works by using chemicals to kill germs on surfaces or objects.
This process does not necessarily clean dirty surfaces or remove germs, but by killing germs on a surface after cleaning, it can further lower the risk of spreading infection.
Clean surfaces and objects using soap and water prior to disinfection.
Does hand sanitizer kill the novel coronavirus?
Hand sanitizer should destroy the novel coronavirus.
Hand sanitizer destroys viruses that are similar to the novel coronavirus, so experts believe it will work against the novel coronavirus, too.
• Hand sanitizer that contains at least 60% alcohol works best. Look for labels with at least 60% ethanol or 70% isopropanol.
• Cover all surfaces of both hands with the sanitizer. Read the package to be sure you’re using the right amount.
• Store and use hand sanitizer carefully, especially around children. Swallowing hand sanitizer can cause alcohol poisoning. Sanitizer also can catch on fire.
• Be sure the hand sanitizer is not on the U.S. Food and Drug Administration's list of hand sanitizers that should not be used. These hand sanitizers have been found to contain toxic ingredients.
What is the best household disinfectant for surfaces during COVID-19?
Regular household cleaning and disinfection products will effectively eliminate the virus from household surfaces. For cleaning and disinfecting households with suspected or confirmed COVID19, surface virucidal disinfectants, such as 0.05% sodium hypochlorite (NaClO) and products based on ethanol (at least 70%), should be used.
How to properly sanitize something to prevent the coronavirus disease?
Hand sanitizers are not intended to replace handwashing in food production and retail settings. Instead, hand sanitizers may be used in addition to or in combination with proper handwashing.
CDC recommends that everyone wash their hands with plain soap and water. Alcohol-based hand sanitizers may be used if plain soap and water are not available. As an interim measure, we understand some food establishments have set up quaternary ammonium hand-dip stations and sprays at 200 ppm concentration.
These products are intended for use on surfaces, and as such, may not be formulated for use on skin. FDA is aware of adverse event reports from consumers using such products as a replacement for hand sanitizers and advises against using these products as replacements for hand sanitizers.
How to Disinfect: The Difference Between Sanitizing and Disinfecting [2021]
16 related questions foundHow should I wash my cloth COVID-19 mask?
Using a washing machine
Include your mask with your regular laundry. Use regular laundry detergent and the appropriate settings according to the fabric label.
By hand
Wash your mask with tap water and laundry detergent or soap. Rinse thoroughly with clean water to remove detergent or soap.
Can I prevent or treat COVID-19 by using disinfectant sprays, wipes, or liquids on my skin?
No. Disinfectants should not be used on human or animal skin. Disinfectants may cause serious skin and eye irritation.
What solutions can be used to disinfect surfaces during the COVID-19 pandemic?
For disinfection, diluted household bleach solutions, alcohol solutions with at least 70% alcohol, and most common EPA-registered disinfectant should be effective.
How can I make my own disinfectant?
DIY sanitizing solution: 5 tablespoons (1/3rd cup) unscented liquid chlorine bleach to 1 gallon of water or 4 teaspoons of bleach per quart of water.
WARNING: Do not use this solution or other disinfecting products on food.
What are some items that I should have at home during COVID-19 pandemic?
When it comes to basic sanitation and hygiene items, try to have bleach, soap, hand sanitizer, antibacterial wipes, face masks, laundry detergent, and garbage bags on hand. You’ll also want to have some basic first aid supplies at home, like an inexpensive digital thermometer, gloves, and bandages.
Be sure to think about the non-food items you regularly purchase at the pharmacy or grocery store and try to have at least two weeks’ worth on hand. This includes toilet paper, toothpaste, tissues, batteries for hearing aids, and contact lens solution.
How long does COVID-19 survive for on clothing?
Research suggests that COVID-19 doesn't survive for long on clothing, compared to hard surfaces, and exposing the virus to heat may shorten its life.
Can rubbing alcohol kill COVID-19?
Many forms of alcohol, including rubbing alcohol, can kill germs. You can dilute alcohol with water (or aloe vera to make hand sanitizer) but be sure to keep an alcohol concentration of around 70% to kill coronaviruses.
What kind of hand sanitation does the CDC recommend?
If soap and water are not readily available, the Centers for Disease Control and Prevention (CDC) recommends consumers use an alcohol-based hand sanitizer that contains at least 60 percent alcohol (also referred to as ethanol or ethyl alcohol).
Consumers are reminded to keep hand sanitizers out of the reach of children and, in case of ingestion, to get medical help or contact a Poison Control Center immediately. Very small amounts of hand sanitizer can be toxic, even lethal, to young children.
How should the facility be cleaned to limit spread of COVID-19?
Cleaning with products containing soap or detergent reduces germs on surfaces and objects by removing contaminants and may also weaken or damage some of the virus particles, which decreases risk of infection from surfaces. Cleaning high touch surfaces and shared objects once a day is usually enough to sufficiently remove virus that may be on surfaces unless someone with confirmed or suspected COVID-19 has been in your facility. For more information on cleaning your facility regularly and cleaning your facility when someone is sick, see Cleaning and Disinfecting Your Facility.
What is the CDC recommendation regarding cleaning surfaces in workplaces during the COVID-19 pandemic?
Routinely clean all frequently touched surfaces in the workplace, such as workstations, keyboards, telephones, handrails, and doorknobs.
If surfaces are dirty, clean them using a detergent or soap and water before you disinfect them.
What disinfectant should be used if soap and water are not available during the COVID-19 pandemic?
• If soap and water are not readily available, use an alcohol-based hand sanitizer that contains at
least 60% alcohol, and wash with soap and water as soon as you can.
Can I use hydrogen peroxide solution to disinfect coronavirus?
A straight 3% hydrogen peroxide solution takes out rhinovirus – which is tougher to kill than coronavirus – in six to eight minutes, and so should be at least as quick in disinfecting coronavirus.
Can I make my own hand sanitizer to prevent the spread of COVID-19?
The FDA does not recommend that consumers make their own hand sanitizer. If made incorrectly, hand sanitizer can be ineffective, and there have been reports of skin burns from homemade hand sanitizer.
What if I don't have any sanitizer during the COVID-19 pandemic?
Washing your hands with soap and water is the recommended method of keeping your hands clean. If soap and water are not available, you can use hand sanitizer, but it must have an alcohol content of at least 60% to be effective.
Can alcohol-based wipes be used to disinfect touch screens during the COVID-19 pandemic?
If no instructions are available from the manufacturer of the device, CDC suggests using alcohol-based wipes or sprays containing at least 70 percent alcohol to disinfect touch screens. You can also take steps to minimize your mobile device's exposure to germs and the coronavirus.
Can we spray disinfectants on streets and sidewalks during the COVID-19 pandemic?
Streets and sidewalks are not considered as routes of infection for COVID-19. Spraying disinfectants, even outdoors, can be noxious for people's health and cause eye, respiratory or skin irritation or damage.
What concentration of bleach should be used to disinfect surfaces from COVID-19 in non-health care settings?
In non-health care settings, sodium hypochlorite (bleach / chlorine) may be used at a recommended concentration of 0.1% or 1,000ppm (1 part of 5% strength household bleach to 49 parts of water). Alcohol at 70-90% can also be used for surface disinfection.
Can I use disinfectant products on my skin to prevent the spread of the coroanavirus disease?
Always follow the instructions on household cleaners. Do not use disinfectant sprays or wipes on your skin because they may cause skin and eye irritation. Disinfectant sprays or wipes are not intended for use on humans or animals. Disinfectant sprays or wipes are intended for use on hard, non-porous surfaces.
Does COVID-19 have an effect on your skin?
Cutaneous illnesses due to SARS-CoV-2 have been rising worldwide. These diseases typically fall into five different patterns, which include maculopapular rash, vesicular rash, pseudo-chilblain, livedo or necrosis, and urticaria. A red rash and urticaria are considered to be the most common manifestations of COVID-19.
Are antiseptic wash products more effective at preventing COVID-19 than plain soap?
There is currently no evidence that consumer antiseptic wash products (also known as antibacterial soaps) are any more effective at preventing illness than washing with plain soap and water.